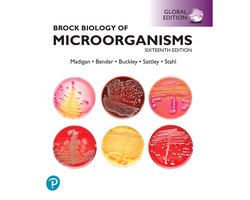
Omslag van Brock Biology of Microorganisms, Global Edition

Boeken zoals: Brock Biology of Microorganisms (text component)
Tips voor lezers van Michael Madigan
Heb je Brock Biology of Microorganisms (text component) gelezen? Of ben je fan van de boeken van Michael Madigan? Dan vind je hieronder een aantal leestips die ook werden gezocht door lezers van 'Brock Biology of Microorganisms (text component)'.

Brock Biology Of Microorganisms
ISBN 9780321536150
The authoritative text for introductory microbiology, Brock Biology of Microorganisms continues its long ...
€ 36.99

Brock Biology Of Microorganisms
ISBN 9781292018317
An introduction to microbiology for biology and microbiology majors. Helping Today's Students Learn ...
€ 24.95
Brock Biology of Microorganisms, Global Edition
ISBN 9781292404790
Get a solid understanding of the major concepts in microbiology with a textbook t hat offers cutting-edge ...
€ 54.39

English Legal Terminology
ISBN 9789089745477
Legal English is a professional language. A good command of ordinary English does not automatically make a ...
€ 22.50

Brock Biology of Microorganisms (text component)
